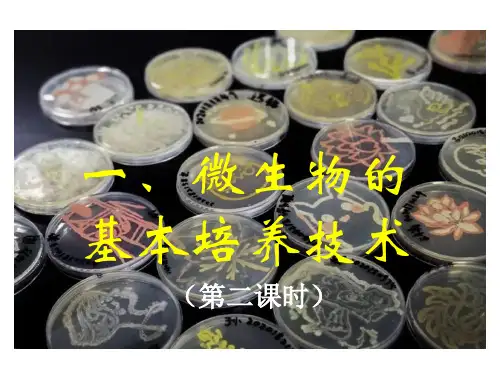

微生物培养技术的形成
- 格式:doc
- 大小:25.00 KB
- 文档页数:3

微生物的培养技术原理与应用前言微生物的培养技术是现代生物学研究中不可或缺的一部分。
通过培养微生物,我们可以深入了解微生物的生理学、生化学以及遗传学特性,从而推动生物医学、生物工程、环境科学等领域的发展。
本文将介绍微生物的培养技术原理与应用。
1. 培养基的选择在培养微生物时,选择合适的培养基非常重要。
培养基需要提供微生物生长所需的营养物质和环境条件。
常见的培养基有以下几种:•富含有机物的培养基:适用于大部分细菌和真菌的培养,如肉汤培养基、LB培养基等。
•富含特定营养物的培养基:适用于特定菌株的培养,如含有特定碳源或氮源的培养基。
•选择性培养基:含有抗生素等抑制其他微生物生长的物质,适用于筛选特定微生物的培养。
•差异培养基:利用微生物对特定物质的利用差异,筛选出特定微生物。
2. 微生物的培养方法微生物的培养方法包括液体培养和固体培养两种形式。
2.1 液体培养液体培养是将微生物直接培养在含有合适营养物的液体培养基中。
液体培养适用于需要大量微生物菌液的情况,如制备纯菌种、生产酶等。
液体培养的步骤如下:1.准备含有合适营养物的液体培养基。
2.将微生物接种到液体培养基中。
3.在适当的温度、湿度和培养时间下培养微生物。
4.根据需要,进行后续的离心、过滤、分离等操作。
2.2 固体培养固体培养是将微生物培养在含有琼脂或洋菜粉的固体培养基上,形成微生物菌落。
固体培养适用于鉴定菌株、观察微生物形态和结构等。
固体培养的步骤如下:1.准备含有琼脂或洋菜粉的固体培养基。
2.将微生物接种到固体培养基上,可以利用平板法或斜面法进行接种。
3.在适当的温度、湿度和培养时间下培养微生物。
4.观察和鉴定微生物的生长情况和形态特征。
3. 微生物的应用领域微生物培养技术在多个领域有着广泛的应用。
3.1 医药领域微生物培养技术在医药领域中被广泛应用于新药筛选、抗菌药物研发、微生物药物生产等方面。
通过培养微生物,可以获得具有药用价值的化合物,并进行进一步的研究和开发。


微生物培养技术第一篇:微生物培养技术的概述细菌、真菌、病毒等微生物是人类生活中普遍存在的微观生物。
由于它们生长速度快、数量多,因此对于科学研究和工业生产都至关重要。
而微生物培养技术则是获取和制备微生物的基础。
本文将详细介绍微生物培养技术的基本概念、培养方法、培养基、培养条件以及操作步骤等。
一、基本概念微生物培养是指将微生物放置在适当的培养基上,通过适当的培养条件使其能够生长和繁殖的过程。
培养技术通常被应用于微生物学、生物工程学、药学、化学工业和环境监测等领域中。
二、培养方法按照培养方法的不同,可以将微生物培养分为无菌培养和无需无菌培养两种。
1、无菌培养无菌培养是指在无菌条件下进行微生物的培养,例如采用高压蒸汽灭菌的方法消除培养器具中的微生物。
这种方法适用于需要进行纯种分离的实验与生产。
2、无需无菌培养无需无菌培养方法则是指在不采用无菌操作的情况下进行微生物的培养。
这种方法适用于少量微生物培养和一些实验的需要。
三、培养基培养基是微生物生长和繁殖所必需的营养物质提供和支持。
培养基的选择与微生物种类、培养条件、培养目的等有关。
基本的培养基种类包括固体培养基、液体培养基和半固体培养基等。
四、培养条件不同种类的微生物对于培养条件的要求也不同,但是基本的培养条件包括以下几点:1、氧气:有些微生物需要氧气才能生长,有些则需要无氧环境。
2、温度:温度影响微生物生长速度和代谢活动,不同菌株对于温度的要求也不同。
3、PH值:微生物对于PH值的适应范围也不同。
4、营养物质:微生物培养需要充足的营养物质,包括碳源、氮源以及其他元素等。
五、操作步骤微生物培养的操作步骤一般包括以下几项:1、选择合适的培养基。
2、准备培养器具并进行消毒。
3、加入适当的微生物接种量。
4、放置在适当的培养条件下培养。
5、对于不同的目的,选择不同的培养时间和方法。
六、总结微生物培养技术在科学研究和工业生产中有着重要的作用。
不同的微生物培养方法和培养条件对于微生物的生长和繁殖有着不同的影响。




微生物的分离与培养技术微生物是指肉眼无法看到的微小生物体,包括细菌、真菌、病毒等。
研究微生物的分离与培养技术对于了解微生物的特性、功能以及应用具有重要意义。
本文将介绍微生物的分离与培养技术的基本原理和步骤。
一、分离微生物的基本原理和方法分离微生物是指从混合微生物群落中将特定微生物种类单独分离出来。
这对于研究微生物种类的多样性和个体差异性非常重要。
下面将介绍两种常用的分离微生物的方法。
1. 肉眼分选法肉眼分选法适用于鉴定和培养易于在富含营养物质的培养基上生长的微生物。
该方法通常用于分离细菌和真菌。
具体步骤如下:a. 首先,将混合微生物群落接种于富含营养物质的琼脂平板上(如营养琼脂平板)。
b. 然后,通过观察生长在琼脂平板上的细菌或真菌的形态、大小、颜色等特征,选择目标微生物。
c. 最后,用无菌的接种环将目标微生物划取到新的培养基上进行单独培养。
2. 稀释涂布法稀释涂布法可用于分离微生物样本中的单个细胞。
该方法适用于细菌和真菌的分离。
具体步骤如下:a. 首先,将微生物样本逐渐稀释至一定浓度。
b. 然后,取少量稀释后的样本使用平板计数法(将稀释后的样本涂布在琼脂平板上,并按照一定比例稀释),以得到适宜的菌落数。
c. 最后,通过观察琼脂平板上的菌落形态,选择目标微生物,并用无菌的接种环将目标微生物划取到新的培养基上进行单独培养。
二、微生物的培养技术培养微生物是为了让细菌、真菌等微生物在富含营养物质的环境中生长和繁殖。
培养技术有助于了解微生物的生长特性和生理特点。
下面将介绍两种常用的微生物培养技术。
1. 液体培养法液体培养法是将微生物接种于富含营养物质的液体培养基中,通过培养瓶或试管中的液体环境,利用微生物对营养物的吸收和转化来进行培养。
具体步骤如下:a. 首先,准备好富含营养物质的液体培养基。
b. 然后,用无菌技术将微生物接种到培养基中。
c. 最后,将培养瓶或试管密封好,放入恒温摇床中,控制培养温度和培养时间,观察微生物的生长情况。

微生物的分离与培养技术原理及其应用-文档资料
微生物的分离与培养技术是微生物学实验室中最基本、最重要的实验技术之一。
其主要原理是将混合微生物群落分离为单一的微生物菌落,并在适宜的环境条件下使其生长繁殖形成单一菌种培养物,以便进行鉴定和研究。
1.微生物的分离技术
(1)稀释涂布法:将微生物混合液逐渐稀释,然后取一定量的稀释液涂布在富养基平板上,待菌落形成后,挑取单一菌落进行培养和研究。
(2)过滤法:利用微孔膜或滤纸将混合液过滤,将过滤后留在微孔膜或滤纸上的微生物进行培养和研究。
(1)液体培养:将微生物接种在富足的液体富养基中,置于适当的温度、光照和通气条件下进行培养。
(3)混合培养:将两种或以上的微生物同时接种在同一富养基上进行培养,这一技术可同时培养多种微生物,缩短实验时间。
3.技术应用
微生物的分离与培养技术在微生物学研究、医学诊断、生物工程和食品工业等领域都得到广泛应用。
(1)微生物学研究:分离单一菌种进行研究,为微生物学研究提供基础。
(2)医学诊断:从临床样品中分离出致病微生物进行培养与鉴定,有助于快速准确地诊断、鉴定和治疗病原微生物感染。
(3)生物工程:在微生物培养基中添加营养物质,用微生物进行合成、代谢和分泌等反应。
(4)食品工业:将微生物培养在富有营养的富养基中进行发酵,生产出发酵食品。

微生物共培养技术的研究与发展一、背景介绍微生物共培养技术(COC)是一种新兴的微生物研究方法,它能够在体外快速、有效地模拟不同环境下多种微生物之间的相互作用,为微生物生态学、环境科学、生物技术等领域的研究和应用提供了重要的手段。
本文将介绍COC技术的原理、方法和应用,以及其在微生物共同培养方面的研究和发展。
二、COC技术的原理和方法COC技术原理主要是将两种或多种微生物放在同一培养物中进行共同培养,在这个过程中微生物之间会产生各种相互作用,从而影响微生物的生长、代谢和功能表现。
为了控制环境变量对微生物之间的影响,COC培养要求对一系列环境变量进行精确控制,包括pH值、温度、氧气浓度、营养物质浓度等。
COC技术方法主要包括两种,一种是液体共培养法,另一种是固体共培养法。
液体共培养法通常使用普通的液体培养基,将两种或多种微生物接种到同一液体培养基中,经过摇床振荡培养后,观察微生物的生长和代谢变化,分析微生物共同作用的结果。
固体共培养法则采用用于生产复杂营养液的固体基质,如KK定量细胞计数法,将微生物接种到这种基质上,经过培养和分析,研究微生物之间的相互作用。
三、COC技术的应用由于COC技术能够模拟真实环境下微生物相互作用的过程,其应用在微生态学、环境科学、生物技术等领域日益受到重视。
以下列出COC技术在这些领域中的应用:1.微生态学COC技术在微生态学领域的应用远远超过其他领域。
在这个领域,COC技术被用于研究微生物之间相互作用的机制,如生态学稳定性、生态恢复、生态破坏等。
COC技术还被用于研究水体、土壤和微生物群落之间的相互作用,从而为生态保护提供了新的手段。
2.环境科学环境科学中的COC技术主要包括污染物降解和生物吸附等方面。
通过COC技术研究微生物之间、微生物与环境之间的相互作用,可以开发出更有效的污染治理方法,从而减少环境污染对生态系统的影响,完善环境质量。
3.生物技术COC技术也被广泛应用于生物技术领域。
微生物纯培养技术
微生物纯培养技术是指在实验室条件下,从一个单细胞繁殖得到的后代中只含有一种微生物的培养技术。
这种技术的目的是获得微生物的纯培养物,以便进行研究和利用。
微生物纯培养技术的关键是防止杂菌污染。
为了实现这一目标,人们按照微生物对营养物质的不同需求,配置出适合其生长繁殖的培养基。
这些培养基不含凝固剂,呈液体状态,被称为液体培养基;如果在液体培养基中加入琼脂后致残,就形成了琼脂固体培养基。
微生物在琼脂固体培养基表面或内部生长,可以形成肉眼可见的菌落。
在进行微生物纯培养时,需要根据不同微生物的特性来选择适当的培养条件。
例如,在培养乳酸杆菌时,需要在培养基中添加维生素;在培养霉菌时,一般需要将培养基调至酸性;在培养细菌时,一般需要将培养基调至中性或弱碱性;而在培养厌氧微生物时,需要提供无氧环境。
微生物纯培养技术是微生物学研究中的重要手段之一,它为微生物的分离、鉴定和研究提供了基础。
微生物培养技术
微生物培养技术是一种用来分离、增殖、培养、监测微生物的技术。
它利用微生物的自然生长和繁殖能力,在合适的培养基和环境条件下,增
殖微生物并获得微生物的相关科学信息,如细菌菌种的分离等。
常见的微生物培养技术:
1.培养基选择。
培养基的选择非常重要,以便使微生物获得最佳的生
长和繁殖环境。
特定的培养基能够有效的激发微生物的生长,没有有害的
病原体出现。
2.培养基的灭菌。
为了保护微生物培养系统,培养基必须经过高温灭
菌处理,以确保没有有害的微生物污染现场。
3.催化剂添加。
催化剂是一种有机物,可以促进微生物的生长和繁殖,从而提高微生物的活性。
4.气体添加。
气体是微生物生长过程中不可或缺的组成部分,它可以
帮助微生物保持正常的运作,调节它们的生理活性。
微生物培养技术正在大量应用于生物技术和医药研究领域,是研究微
生物的重要工具。
通过这种技术,可以有效的分离出各种微生物菌株,并
获得相关科学信息,为研究微生物及其生物功能奠定基础。
微生物培养技术微生物培养技术微生物培养技术是指将微生物置于适宜的培养基中,利用适当的条件创造合适的生长环境,促进微生物繁殖和生长的一种方法。
微生物分为细菌、真菌、病毒、放线菌等等,细菌和真菌是常见的微生物,广泛存在于自然中,有益于人类,也有害于人类。
对于细菌和真菌进行培养,可以让人们更全面地了解微生物的生物学特性和生长规律,为科学研究、医学诊断、工业生产等方面提供重要的基础。
下面将从微生物的培养介绍、培养基的种类及制备方法的讲解、培养条件的重要性和细菌与真菌的常见培养方法四个方面进行阐述。
一、微生物的培养介绍微生物的培养可分为液体培养和固体培养两个方式,其中固体培养使用更广泛,主要包括两种:琼脂平板和斜面培养。
琼脂平板培养是将琼脂培养基倒入平板容器中,凉透凝固后,将微生物接种于琼脂之上,使之均匀分布。
将琼脂平板倒置放在温度适宜的培养箱内,使其在适宜的温度下生长。
可通过观察、计数、分离、纯化、鉴定、筛选等方法来进行实验研究。
斜面培养也是使用琼脂培养基,将其胶化后倒在倾斜的试管中,待凝固后接种微生物于斜面之上。
该方法可以使微生物的营养分布相对均衡,而不受重力影响,有利于细菌的生长。
这种方法更适用于保存微生物菌种。
二、培养基的种类及制备方法不同的微生物需要对应不同的培养基,细菌的培养基中的不同成分需要设置不同的比例,以满足细菌的需要。
常用培养基有气体培养基、富含营养物质的培养基、复合培养基、不同菌群特异培养基等,这些培养基各自的成分配比不同,具有各自的特殊功能。
滴定法、蒸馏法、电解法及化学分析法等是一些制备方法,各种物质的加入比例应该根据培养基的类型、微生物的特点、培养的目的和需要来合理选择。
三、培养条件的重要性常见的培养条件包括温度、pH值、营养成分、氧气和湿度。
不同的细菌和真菌适合不同的生长条件,温度是微生物生长的主要限制因素,大部分细菌和真菌的最适生长温度为30°C~37°C;pH值也是影响微生物生长的重要因素之一,不同的微生物在不同的条件下生长所用的pH值也不同;营养成分是培养基必不可少的成分之一,细菌和真菌吸收的营养有所不同,根据微生物的要求调整培养基的营养成分比例,可以最大化地提高培养效果。
摘要: 遍布于地球上各种生境中的微生物具有丰富的物种多样性。
迄今为止, 能够在实验室条件下培养的微生物仅仅是其中的一小部分, 微生物物种的绝大多数还都难以在现有培养技术和条件下进行繁殖和生长。
人们把那些尚未在实验室获得培养生长的微生物称之为未培养微生物(Uncultured microorganisms) 。
对未培养的微生物的研究方兴未艾, 主要是讨论有关环境微生物的遗传多样性分析等。
本文概述了一些制约微生物培养生长的影响因素, 重点介绍了近年来出现的一些新颖独特的环境微生物培养技术和方法, 包括稀释培养法、高通量培养技术、模拟自然环境的扩散盒技术等。
这些新颖培养技术和培养方法的出现, 显著提高了微生物的可培养性, 发现和鉴定了许多新的微生物物种, 极大地丰富了可培养微生物的多样性和微生物资源, 并为深入研究和开发微生物奠定了良好的资源研究基础。
关键词: 环境微生物, 未培养微生物, 新培养技术微生物培养技术的形成, 奠定了微生物分类、生理、遗传等当代微生物学各个领域发展的基础。
研究和分析表明, 自然界中绝大多数微生物在现有条件下尚不能被传统的微生物技术培养出来, 依照现有的培养技术和方法, 不同生境微生物可培养率的检测结果是: 海水中约为0.001%−0.1%, 淡水中约为0.25%, 土壤中约为0.3%, 活性污泥中约为1%−15%。
人们把那些在现有培养技术条件下尚未获得培养生长的微生物泛称为未培养微生物(Uncultured microorganisms)。
研究表明, 自然界中微生物的多样性远远超过了以前人们的想象。
现在人们一般认为, 环境微生物中99%以上是尚未能被培养的。
在原核生物的40个分类门中, 有一半还没有纯培养出代表种。
尽管人们还无法分离培养大部分的微生物, 但是可以绕过培养障碍, 通过运用分子生物学的手段来鉴定某些未知的微生物, 这在探究原因不明的传染病时特别有用。
环境中绝大部分的微生物还不被人类所认识, 这暗示其中蕴含着大量未知的遗传信息。
从未培养的微生物中克隆新的基因, 已逐渐成为近年一大研究热点领域, 也获得了相当的成果, 得到了许多功能更强、结构更新的基因及基因家族。
概括起来主要有两种方法。
第1种是鸟枪法。
第2种方法是PCR扩增法。
两种方法各有优缺点: 用鸟枪法得到新的基因(特别是新的基因家族) 的可能性较大, 但是需要构建较大的基因文库, 筛选的工作量大, 且容易漏筛活性较弱的克隆菌以及表达载体不适合的基因; PCR扩增法比较简单, 工作量较小, 但需要用已知基因的保守序列作为引物, 因而发现新的基因家族的可能性也较小。
为了克服两种方法的不足, 有的学者把两者结合起来。
他们对PCR法进行改良,采用的引物不是某一个特定基因的序列, 而是一些伴随基因的可移动元件的保守序列,如质粒、转座子、整合子等。
这种方法结合了传统鸟枪法和PCR法的优点, 既减少了筛选的工作量, 又能得到较多的新基因及新基因家族。
但是, 由于没有明确的功能基因指向, 利用这种方法得到的多半是些功能未知的基因。
研究者开发出一系列不依赖微生物培养技术的研究方法, 例如变性梯度胶凝胶电泳(DGGE)、荧光标记细菌寡核苷酸探针细胞原位杂交(FISH)、DNA 芯片、宏基因组测序分析等。
不过, 该类方法也同时带来本身固有的弊端。
例如, 对微生物从细胞水平上呈现出的形态特征、生理特性、代谢功能、环境胁迫效应的生物应答等, 难以进行实验研究, 致使无法准确了解微生物细胞的生命活动; 难以对微生物群落中不同种群间的相互作用、相互协调的动态过程和变化规律进行科学描述和验证, 进而无法对环境微生物工艺过程进行准确设计、精细调控和高效利用。
因此, 在利用分子生物学技术研究微生物多样性、开发环境微生物基因资源的同时,需要不断研发新的微生物培养技术, 使以往被认为是不可培养的微生物源源不断地融入到可培养的行列之中, 才能真正深入和有效地研究和发现微生物生理遗传等生命规律, 实现微生物资源的开发和利用。
1 制约微生物培养生长的因素地球上微生物生存的环境类型多种多样, 除了普通的自然环境外, 还存在着各种极端环境, 海洋热液喷口(Deep-sea hydrothermal vent) 就是典型的极端生境之一。
由于这种极端环境条件下的众多复杂因素, 特别是深海高压的限制, 人工条件下还无法完全模拟自然环境, 因此, 许多微生物仍然是不可培养的, 对其物种多样性和系统发育树的研究主要依赖于分子生物学的方法。
为了实现既定的研究目的, 人们通常将微生物限定在营养基质简单、通气、温度、pH 等参数恒定的条件下培养, 许多微生物就此丧失了自由生长的必要条件, 从而表现为不可培养。
在环境中, 共代谢对于建立两个种群间的偏利共生关系起着很重要的作用, 尤其在农药、人工合成染料、石油烃类等有机污染环境中, 通常作为生物降解的重要途径。
当微生物从自然环境转移到营养丰富的人工培养基中时, 一些摄取营养能力强的微生物会应运而生, 而寡营养的微生物就会因高浓度营养物基质的抑制而停止生长。
2改善微生物培养的新方法2.1 稀释培养法(Dilution culture)在地球上, 许多生境处于低营养或寡营养的状态, 海洋就是典型的寡营养环境之一, 海洋中占主体的寡营养微生物, 在人工培养时往往受到少数优势生长微生物的竞争而不能正常生长。
针对这种缺陷, 1993 年, Button 等提出, 当把海水中微生物群体稀释至痕量时, 海水中的寡营养微生物可以不受少数几种优势微生物竞争作用的干扰, 被培养的可能性会大大提高。
作者采用稀释培养法结合流式细胞仪计量研究了海洋细菌的多样性, 结果表明, 稀释培养9 周后的微生物细胞浓度可达到104/mL, 细胞的倍增时间差异明显, 短的只需一天, 长的可达一周。
该种稀释培养方法同样也被应用于淡水湖泊的微生物生态学研究中。
2005年, 戴欣等在研究我国太湖水环境富营养化的过程中, 比较了水体细菌在普通培养基和稀释培养基上的分离效果, 发现在稀释培养基上生长的细菌数量是富营养的牛肉汁蛋白胨琼脂培养基上生长数量的3 −5倍。
2011 年, Kenters 等将羊胃中的微生物样品液稀释至极限梯度(10−10−10−12) 后, 接种到一种自制的含有羊胃内容物的接近原生境的培养基中培养, 在长有细菌的近140 个试管中, 58% 的为纯培养, 大部分菌株的16S rRNA 基因序列相似性为88% −94%, 均为未报道过的新种或新属。
2.2 高通量培养技术(High-throughput cultivation, HTC)为了提高细菌的分离效率, Connon 等在稀释培养法的基础上提出高通量培养技术, 该方法是将样品浓度稀释至103/mL 后, 采用48孔细胞培养板并结合流式细胞仪检测分离培养微生物。
该方法不仅有效的提高了微生物的可培养性, 还可在短期内监测大量的培养物, 大大提高了工作效率。
2.3 模拟自然环境的培养技术2.3.1 扩散盒培养技术(Diffusion growth cham-ber): 为了能够让海洋微生物在原位条件下富集生长, 最终得到纯培养的微生物, Kaeberlein 等在分离培养海岸潮间带底泥中的微生物时, 使用一种新颖的名为扩散盒的自制培养仪器, 它是由一个环状的不锈钢垫圈和两侧胶连的孔径为0.03 μm 的滤膜组成, 滤膜只允许培养环境中的化学物质流通而不能让细胞通过。
应当指出, 扩散盒技术初次培养获得的微小菌落多数为混合培养, 通常需要再次分离, 才能获得纯培养。
该种方法的特点是: 模拟自然环境, 不同细胞间经过互喂(Cross-feeding), 形成独立的菌落。
2.3.2 细胞微囊包埋技术(Microencapsulation): 细胞微囊包埋法是近年来出现的一种将单细胞包埋培养与流式细胞仪检测结合为一体的高通量分离培养技术。
细胞微囊包埋法的优点是: 在接近于天然生长的环境中有效地提高了微生物的可培养性, 但由于该方法建立时间较短, 还存在一些如包埋基质机械强度低, 透性差、微生物热敏感等技术问题, 且成本较高, 在国内也还处于实验研究阶段, 尚需不断的改进。
2.4 改良微生物培养基组成和培养条件微生物多样性表现出生理代谢的多样性及复杂性, 不同的微生物生长谢类型不同, 对反应的底物要求也存在差异。
因此, 根据微生物的某些特性, 在传统的培养方法基础上, 有选择性的添加微生物生长所必需的营养成分, 从而使原先无法培养的变成为可培养的。
3 结束语综上所述, 近年来, 新颖的微生物培养方法和技术陆续问世, 大致上可归纳为两类: 一是在传统的培养基组成和培养方式上进行改良, 包括添加微生物相互作用的信号分子, 供应新型的电子供体和受体, 降低营养基质浓度, 延长培养时间以改善微生物的培养条件促进低营养以及寡营养微生物种类的分离培养等; 第二是设计仿原生境的高通量微生物培养技术和装置, 诸如用于海洋环境和陆生环境的扩散盒技术, 土壤基质膜技术以及高通量的微生物分离芯片等。
然而, 尽管业已取得了上述令人瞩目的进展, 人们也清醒的认识到, 由于微生物生存环境的极其复杂性, 未培养微生物数量巨大, 种类繁多的现实性, 因此, 在探索微生物神奇世界的征途上仍旧面临着巨大的挑战。
总之, 由于微生物群落及其生存环境的复杂性, 在进行新培养技术的研发和实际应用时, 无需限定于其中的一种或一类方法, 而应综合考虑, 采用多种行之有效的技术方法。
同时, 新型培养技术的研发还应结合相关的分子生物学技术, 以及其他学科的理论和实验技术, 取长补短, 相辅相成, 藉此才能更好的拓展微生物的可培养性, 通过不懈的努力, 争取培养出更多的“未培养微生物”。
参考文献[1]王保军,刘双江。
环境微生物培养新技术的研究进展[J]. 微生物学通报,Jan. 20, 2013,40(1): 617 。
[2] 刘利. 未培养微生物的研究方法[J]. 贺州学院学报, 2007, 23(2): 119 − 121.[3] 郭斌, 吴晓磊, 钱易. 提高微生物可培养性的方法和措施[J]. 微生物学报, 2006, 46(3): 504 − 507.[4] 胡俊, 万欢, 吴根福. 环境中未培养微生物的研究进展[J]. 农机化研究, 2007(8): 1 − 3, 38.[5] Rappé MS, Giovannoni SJ. The uncultured microbial majority[J]. Annual Review of Microbiology, 2003, 57: 309− 394.[6]蓝希钳,周泽扬。